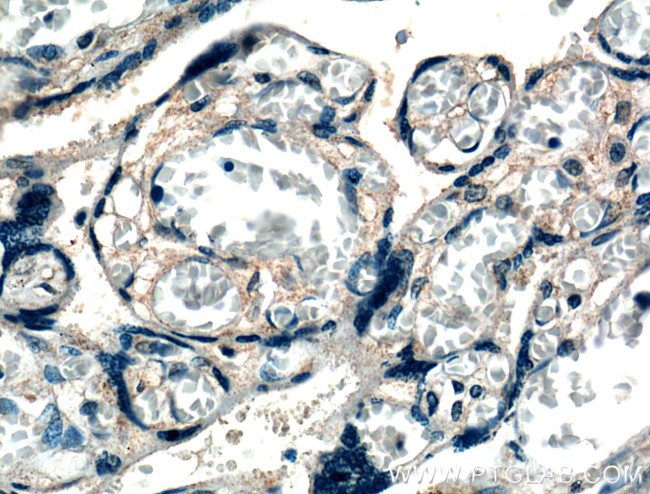
XKRX Antibody in Immunohistochemistry (Paraffin) (IHC (P))

Search
Proteintech
XKRX Polyclonal Antibody
{{$productOrderCtrl.translations['antibody.pdp.commerceCard.promotion.promotions']}}
{{$productOrderCtrl.translations['antibody.pdp.commerceCard.promotion.viewpromo']}}
{{$productOrderCtrl.translations['antibody.pdp.commerceCard.promotion.promocode']}}: {{promo.promoCode}} {{promo.promoTitle}} {{promo.promoDescription}}. {{$productOrderCtrl.translations['antibody.pdp.commerceCard.promotion.learnmore']}}
产品信息
27049-1-AP
种属反应
宿主/亚型
分类
类型
抗原
偶联物
形式
浓度
规格
纯化类型
保存液
内含物
保存条件
运输条件
产品详细信息
Immunogen sequence: VHRDLAKDK PLSLFMHLIL LGPVIRCLEA MIKYLTLWKK EEQEEPYVSL TRKKMLIDGE EVLIEWEVGH SIRTLAMHRN AYKRMSQIQA FLGSVPQLTY QLYVSLISAE V (101-210 aa encoded by BC137010)
靶标信息
This gene encodes a protein that is related to a component of the XK/Kell complex of the Kell blood group system. The encoded protein includes several transmembrane domains, is known to be exposed to the cell surface, and may function as a membrane transporter.
仅用于科研。不用于诊断过程。未经明确授权不得转售。
篇参考文献 (0)
生物信息学
蛋白别名: Membrane protein XPLAC; unnamed protein product; X Kell blood group precursor-related, X-linked; X Kell blood group-related, X-linked; X-linked Kx blood group related, X-linked; XK, Kell blood group complex subunit-related, X-linked; XK-related protein 2; XRG2
基因别名: XKR2; XKRX; XPLAC; XRG2
UniProt ID: (Human) Q6PP77
Entrez Gene ID: (Human) 402415